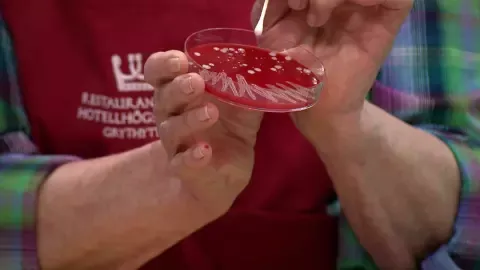

Professor Marie-Louise Danielsson-Tham, specialist op het gebied van voedselhygiëne, was onlangs te gast bij het tv-programma Nyhetsmorgon om te praten over hygiëne in de keuken.
Haar opvallende waarschuwing en demonstratie over een veelgebruikt keukenhulpmiddel zetten ons echt aan het denken.
Volgens haar: “In elk klein plekje op de plank zitten tussen de één en tien miljoen bacteriën. Het is dus lang niet zo hygiënisch als velen denken,” zei ze tijdens het interview.
Het onderwerp keukenhygiëne is actueler dan ooit. Tijdens haar bezoek aan Nyhetsmorgon maakte professor Danielsson-Tham korte metten met een mythe en legde uit waarom één specifiek keukengerei — de houten snijplank — verraderlijk ongezond kan zijn. Zeker in 2025 zijn dit inzichten die u niet kunt negeren.
Waarom u beter afscheid neemt van de houten snijplank
Het draait allemaal om de houten snijplank. Ondanks zijn stijlvolle uitstraling en populariteit is deze plank geen ‘zelfreinigend’ wonder, zoals velen denken.
Door herhaald gebruik ontstaan er scheurtjes in het hout — dat is precies waar het risico zit. In deze smalle barstjes nestelen zich bacteriën diep in, die je er nauwelijks meer uitkrijgt.
Vooral als u rauwe kip of vlees op zo’n plank snijdt, kunnen er gevaarlijke bacteriën achterblijven in de scheuren. Snijdt u daarna bijvoorbeeld tomaten, komkommer of gewoon vers brood op dezelfde plank? Dan lopen die bacteriën zo mee uw maaltijd in — en uiteindelijk in uw lijf.
In Nederland zien we, net als in Zweden, dat bacteriën als EHEC — vaak afkomstig van rauw vlees — opmars maken. Deze bacterie is zelfs besmettelijker dan salmonella en kan felle buikkrampen en diarree veroorzaken. Schrikbarend detail: slechts tien EHEC-bacteriën volstaan om volwassen mensen ziek te maken.
Professor Danielsson-Tham adviseert daarom om houten snijplanken hooguit nog voor brood te gebruiken. Meer niet.

Daarom zijn houten snijplanken een bron van bacteriën
Naast het feit dat houten snijplanken er fraai uitzien op uw Haagse of Amsterdamse keukenfoto’s, laat de dagelijkse praktijk iets anders zien. Ze kunnen namelijk niet in de vaatwasser — en grondig schoonmaken met de hand? Alleen als u ze een half uur in 60-graden water legt. Zelfs dan blijft het lastig om álle bacteriën uit de scheuren te krijgen.
Danielsson-Tham liet dat zien met een kweekschotel: ze haalde een steriel wattenstaafje door een oude snee, zette die in een voedingsbodem en liet het resultaat zien. Een schrikbarend beeld.
“In elke vlek op de kweek groeien tussen een en tien miljoen bacteriën op. Zo fris is die plank dus niet,” aldus de professor.
Advies van de expert: zo vaak moet u uw snijplanken vervangen
Wat kunt u dan het beste doen? Kies plastic snijplanken. Niet het meest duurzaam, maar wél veel hygiënischer volgens voedselveiligheidsexperts.
Makkelijk tip: Gebruik verschillende kleuren snijplanken voor vlees, vis en groenten. Bij Appie of HEMA vind je handige sets — dat voorkomt verwarring en kruisbesmetting.
En wees niet te zuinig — vervang snijplanken gerust 2 tot 3 keer per jaar. Houten designerplanken mogen voor het borreluur blijven, maar niet voor rauw vlees of groente.
Meer zien? Bekijk het volledige Nyhetsmorgon-item met Marie-Louise Danielsson-Tham — even Googlen en je vindt ’t zo terug!
